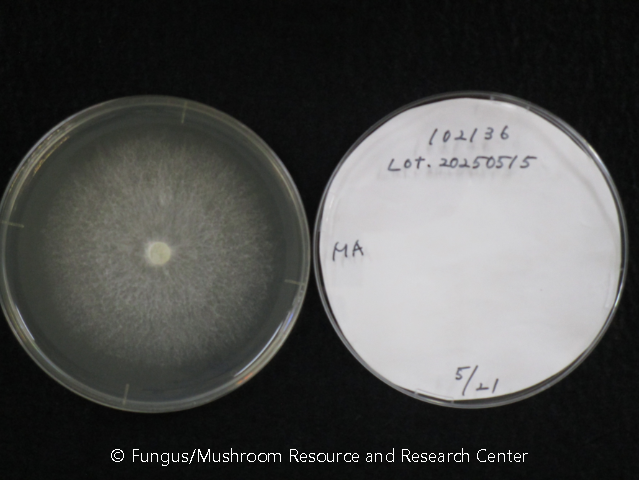

分類情報
- TUFC No.
- 101236
- 門
- Basidiomycota
- 綱
- Agaricomycetes
- 亜綱
- 目
- Russulales
- 菌名
- Russula violeipes Quél.
- 和名
- ケショウハツ
- 受入れ菌名
- Russula violeipes
寄託情報、菌株来歴等
- 寄託年月日
- 2017年01月20日
- 登録者
- K. Sotome
- 寄託者
- A. Nakagiri & N. Endo
- 寄託者所属
- FMRC
- 菌株来歴
- <- A. Nakagiri & N. Endo (FMRC, ShoY2016062902) <- S. Yamane (FATU, ShoY2016062902)
- 他の菌株番号
- ShoY2016062902
採集者、分離源情報等
- 採集者名
- S. Yamane
- 採集者所属
- FATU
- 採集年月日
- 2016年06月29日
- 同定者名
- N. Endo
- 同定者所属
- FMRC
- 同定年月日
- 2016年06月29日
- 分離者名
- S. Yamane
- 分離者所属
- FATU
- 分離年月日
- 2016年06月29日
- 分離源
- Basidioma
- 分離法
- Tissue isolation
採集地
- 基質・宿主
- On the ground in broad-leaved tree forest
- 場所
- Koyama-cho, Tottori-shi, Tottori Pref., Japan
標本情報
- 標本番号(TUMH)
- 62672
関連画像
シークエンス情報
- 領域 2
- LSU
- シーケンスデータ 2
- >101236_lsu_20170303_AE AATTTAAAATCTGGTGGCCTTTGGTCATCCGAGTTGTAATTTAGAGAAGCGTCTTCCGCGCTGAACCGTGCACAAGTCTCCTGGAATGGAGCGTCATAGAGGGTGAGAATCCCGTCTTTGGCACGGAACATCAGGGCTTCTGTGATGCGCTCTCGACGAGTCGAGTTGTTTGGGAATGCAGCTCAAAATGGGTGGTGAACTCCATCTAAAGCTAAATATTGGCGAGAGACCGATAGCGAACAAGTACCGTGAGGGAAAGATGAAAAGCACTTTGGAAAGAGAGTGAAACAGTACGTGAAATTGTTGAAAGGGAAACGCTTGAAGTCAGTCGCGTCGACCGAGACTCAGCCTTGCCTTGGCTTGGTGTACTTCTCGGCTTGACGGGTCAGCATCAATTTTGGTCCTCGGATAATGGCAAGGGAAAGGTAGCACCTTTTCAGGTGTGTTATAGTCCTTTGTCGCATACGGGGGCTGGGATTGAGGAACTCAGCACGCACCTTTAGGTGTCGGGGCCTCGGCCCACGATACGTGCTTAGGATGCTGGCGTAATGGCTTTAAACGACCCGTCTTGAAACACGGACCAAGGAGTCTAACATACCCGCGAGTGTTCGGGTGGAAAACCCGTGCGCGTAATGAAAGTGAAAGTTGGGACCTCTGTCGTGGAGGGCACCGACGCCCGGACCAGACCTTCTGTGACGGCCCTGCGGTAGAGCGTGTATGTTGGGACCCGAAAGATGGTGAACTATGCCTGAATAGGGTGAAGCCAGAGGAAACTCTGGTGGAGGCTCGTAGCGATTCTGACGTGCAAATCGATCGTCAAA
※本ウェブサイトに掲載されている情報、写真、動画、図表は、全てオリジナルであり、鳥取大学農学部附属菌類きのこ遺伝資源研究センターに帰属します。著作権法において認められている個人的な使用の範囲を超えて、無断で複製、使用することはできません。
文献
その他
- BSLレベル
- L1
- 物理的封じ込めレベル
- P1
- 培地
- MNC
- 培養温度
- 20 ℃
- 公開日
- 2021年07月14日
- 最終更新日
- 2025年06月11日